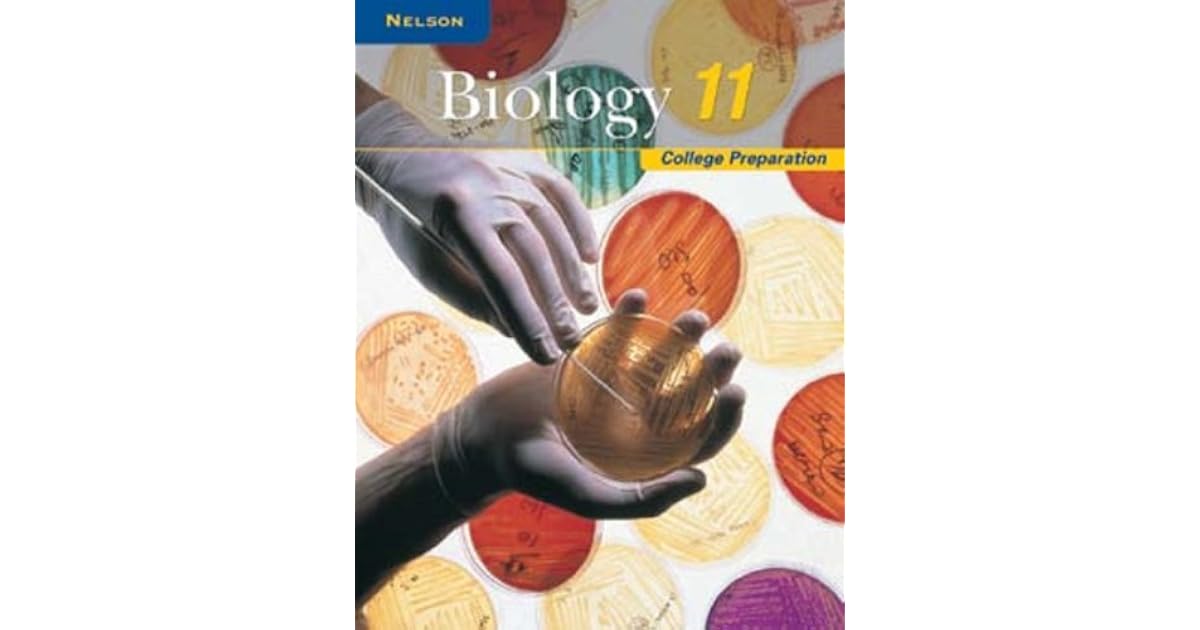

Grade 11 Biology Textbook with online PDF, Ontario Curriculum, Academic. Nelson Biology 11 Textbook with online PDF; Back. Nelson Biology 11 Textbook with online PDF. ISBN : 9780176510367, 0176510362 Author : Doug Fraser. Publication date : 2010. $140.95. Qty: Add to Cart. REQUEST USED BOOK.. Find step-by-step solutions and answers to Nelson Biology 11 – 9780176510367, as well as thousands of textbooks so you can move forward with confidence.. More textbook info. Barry LeDrew, Doug Fraser, Jacqueline Dulson. ISBN: 9780176510367. Barry LeDrew, Doug Fraser, Jacqueline Dulson. Textbook solutions. Verified. Chapter 1:Understanding.

Nelson Biology 11 College Preparation Solutions Manual 9780176269685 Nelson

Myanmar Grade 10 Biology 2 Textbook (Practical Workbook) LearnBig

Nelson Biology 11 Nelson

Biology 10 Chapter 10 Mcqs Test 3 Fbise Solved Past Papers www.vrogue.co

Nelson Textbook of Pediatrics, 2Volume Set, 21st Edition Vasiliadis Medical Books

(PDF) MCQ in Pediatrics Review of Nelson textbook of Pediatrics

Nelson Biology 11 University Preparation Nelson

Nelson Biology 11 Solutions Manual Nelson

Biology 11 (McGraw Hill) Nelson

Biology 11 Unit 1 Answers Biology 11 Answer Key Unit 1 • MHR TR 1 Unit 1 Diversity of Living

Chemistry 11 (McGraw Hill) Nelson
Nelson Biology 11 College Preparation Student Workbook by Maurice DiGiuseppe

BETTER Descargar Libro Ginecologia Perez Sanchez Pdf 20

Nelson Biology 12 Student Book 9780176259877 Nelson

A Textbook Book Of Biology Class 11 Buy A Textbook Book Of Biology Class 11 by Chaudhuri

Ncert Class Xi Biology Chapter 6 Anatomy Of Flowering Plants Photos

Nelson Biology VCE Units 3 & 4 (1 Access Code Card); 3 Edition; ISBN 9780170368711

Save The Creatures Download For Mobile kylefab

Correlation of Nelson Biology 11 to The Ontario Curriculum

Oxford Biology PNG Upper Secondary Grade 11 Theodist Theodist
Key Features: – High interest STSE based special features including Biology Connections and Case Studies. – Supports understanding of rigourous content with frequent learning checks and extensive section review summaries and questions. – Study guide helps students to focus their review time where they need it most and to build effective study.. McGraw-Hill Ryerson Biology 11, Teacher’s Resource Corresponding teacher’s guide for. ISBN: 9780071051057. Publication Date: 2011. Nelson Biology 11: University Preparation by Maurice DiGiuseppe, Jacqueline Dulson This textbook supports the 2008 Ontario science. The book features 11 units, covering all the body’s systems-such as.